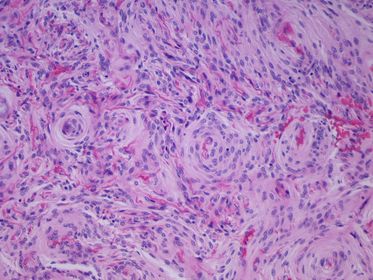

Medicina Dermatología Flashcards on Repaso dermatología, created by Olivares_94 on 18/02/2016.
Pinned to
2661
2
0
No tags specified
|
|
Created by Olivares_94
over 9 years ago
|
|
Close
|
|
Created by Olivares_94
over 9 years ago
|
|

¿Cómo se denomina éste instrumento empleado para la biopsia cutánea?

¿Cómo se denomina a éste tipo de lesión de falta de continuidad de la piel?

¿Cuáles son los tipos de úlcera por su morfología?

Paciente que llega a urgencias con una lesión elevada y circunscrita de tipo fugaz

¿Cuál es esta técnica de biopsia?

¿De qué patología se trata?

¿Marcas que podemos grabar por presión en un individuo con habones o urticaria?

¿Cómo se denomina al halo blanquecino que aparece alrededor de las lesiones de la psoriasis?

¿Cómo se llama la técnica diagnóstica que deja lesiones en 3 fases: signo de vela, signo de membrana y signo de rocío hemorrágico?

¿De qué lesión elemental, agrupación y patología se trata?

Paciente que refiere que la piel se le ha vuelto más fina con los años

¿De qué lesión elemental se trata?

Paciente que refiere desde nacimiento este tipo de lesión oscura ¿De qué se trata?

¿Cuáles son los tipos de lesiones elementales por falta de continuidad

¿Lesión de contenido líquido de gran tamaño? ¿Y de pequeño tamaño?

Paciente que llega con lesión de contenido líquido y con pared palpable en cuero cabelludo. ¿Qué es?

¿Qué técnica estamos usando?

¿Lesión elevada, <1 cm., que no deja

¿Lesión no elevada, rojiza y caliente?

¿Qué técnica estamos empleando?

¿Lesión que no desaparece a la vitropresión?

¿Lesión elemental debida a dilatación que desaparece a la vitropresión?

Paciente que llega a consulta con estas lesiones rojizas:

¿Qué técnica estamos empleando?

. Paciente que llega con eritema universal ¿qué otro nombre recibe? ¿Es grave?

¿Lesión histológica fruto de la destrucción de conexiones intercelulares? ¿Qué lesión elemental produce?

Lesión con edema intercelular: ¿Espongiosis o acantolisis?

¿Qué tipo de ampolla es?

¿Cómo se llama la lesión histológica en la que los queratinocitos basales se llenan de agua? ¿Qué tinción se emplea para ver la capa basal?

¿Cómo se denomina la incursión atípica de la dermis sobre la epidermis?

¿Cómo se denomina al aumento del espesor de la capa córnea?

¿Qué lesión tiende al endurecimiento y no desplazamiento sobre los planos inferiores?
Paciente con lesiones anulares, que tiene contacto con animales, presenta lesiones en capa cornea y en tinción de PAS se revela esta imagen. ¿Qué es?

¿De qué técnica se trata?

¿Qué técnica/signo es?

¿Qué técnica estamos usando?

¿Qué lesión podemos ver en la imagen?

Lesiones duras al tacto más las lesiones que aparecen en la imagen. ¿De qué dos lesiones se trata? ¿En qué cuadro clínico pueden enmarcarse?

¿Qué lesiones elementales observamos? ¿De qué patología se trata? ¿Qué examen complementario usaríamos?

Eritema universal asociado a escamas. Esta asociación es frecuente. ¿Con qué cuadros dermatológicos son compatibles ?

Paciente con lesiones blanquecinas en el tronco. ¿Qué lesión elemental es?

¿Qué tipo de distribución presenta esta lesión? ¿De qué agente infeccioso es típico?

¿Qué tipo de distribución presenta esta lesión?

. ¿Qué morfología presentan estas lesiones?

¿Qué morfología presentan esta lesión?

Lesión que no desaparece con la vitropresión:

Lesiones en ambas piernas situadas en el tejido celular subcutáneo:

. ¿Qué disposición tiene esta lesión?

Para qué técnica terapéutica dermatológica se emplea este aparato:

Lesión elemental que puede formarse por espongiosis o por degeneración balonizante, ¿Qué lesión elemental es?

Cómo se llaman las vesículas llenas de pus?

¿Cómo se llama esta lesión elemental debida a una vasodilatación capilar permanente?

¿Qué tipo de lesión elemental es? ¿Qué exámenes complementarios debemos realizar? ¿Cuál es el posible diagnóstico?

¿Cómo se denomina esta lesión elemental?

Lesiones elevadas llenas de líquido y lesión de continuidad. ¿Qué son? Si tuviese un signo Nikolsky +, ¿histología? ¿Cuadro clínico compatible?

¿Qué lesión tiene tendencia a crecer y permanecer indefinidamente?

¿Cómo se denomina esta prueba?

¿Cómo se llama esa prueba?

¿Cómo se llama esa prueba?

¿Técnica diagnóstica en el que tomamos una muestra del contenido líquido de una vesícula y lo teñimos con tinción Giemsa?

Paciente con cuadro pruriginoso con surco acarino. ¿Cómo se llama la patología?

Paciente con una mastocitosis en el que a frotar las lesiones aparece un habón. ¿Cómo se llama este signo?


 Hide known cards
Hide known cards